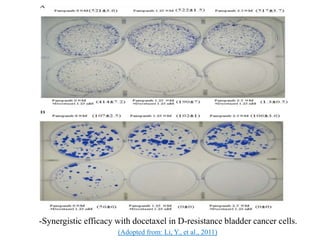
(Adopted from: Li, Y., et al., 2011)
-Synergistic efficacy with docetaxel in D-resistance bladder cancer cells.

Biological agents are substances derived from living organisms that are used clinically for disease prevention, diagnosis, and treatment. This document discusses several types of biological agents including monoclonal antibodies, interleukins, interferons, and protein kinase inhibitors. It provides examples of specific drugs, describes their mechanisms of action and clinical applications. While biological agents demonstrate promising results in cancer treatment, their development and production is complex and costs are currently high compared to conventional chemotherapy.

![References
Aubin F, et al, The complexity of adverse side-effects to biological agents, Journal of Crohn's and Colitis (2012), doi:10.1016/j.crohns.2012.06.024
Bukowski, R.M., Yasothan, U. and Kikpatrick, P. (2010) Pazopanib [Online]: 9 pp.17-1823-25, Available from: http://www.sciencedirect.com/
[Accessed: 20/10/2012].
Burge, R. A., Brady, M. F. & Bookman, M. A., 2010. Phase III trial of bevacizumab (BEV) in the primary treatment of advanced epithelial ovarian
cancer (EOC), primary peritoneal cancer (PPC), or fallopian tube cancer (FTC): A Gynecologic Oncology Group study.. J Clin Oncol, 28(18).
Cancer research UK. (2012). Cancer growth blockers. [online]. Available at: <http://cancerhelp.cancerresearchuk.org/about-
cancer/treatment/biological/types/cancer-growth-blockers> [accessed 19 Oct. 2012]
Gardlik, R., Celec, M. & Bernadic, M., 2011. Targeting angiogenesis for cancer (gene) therapy. Bratisl Lek Listy, 112(8), pp. 428-434
Li, Y., Yang, X., Su, L., and Flaig, T. N.D.,(2011) Pazopanib Synergizes with Docetaxel in the Treatment of Bladder Cancer Cells[Online]: Urology
78(1) pp. 233.e7-233.e13 , Available from: http://www.ncbi.nlm.nih.gov/pubmed/ [Accessed: 13/10/2012]
National Cancer Institute (N/A), Introduction to biological therapy,[ online] available at: http://training.seer.cancer.gov/treatment/biotherapy/, [Accessed
28 Oct 2012].
Navid, F., 2012. Nationa Cancer Institute. [Online]
Available at: http://www.cancer.gov/clinicaltrials/search/view?cdrid=595267&version=HealthProfessional
[Accessed 28 10 2012].
NCI, 2004. National Cancer Institute. [Online] Available at: http://www.cancer.gov/cancertopics/treatment/biologicaltherapy [Accessed 30 10 2012].
Pazdu, R., 2011. National Cancer Institute. [Online]
Available at: http://www.cancer.gov/cancertopics/druginfo/fda-bevacizumab
[Accessed 21 10 2012].
Pick, A.M. and Nystrom, K.K. (2012) Pazopanib for the treatment of metastatic renal cell carcinoma[Online]:34 (3) pp. 511-520 23-25, Available from:
http://www.sciencedirect.com/ [Accessed: 25/10/2012].
Rieger, P. (2001). Biotherapy: a comprehensive overview. 2nd ed. London: Jones and Bartlett Publisher.
Shih, T. & Lindley, C., 2006. Bevacizumab: an angiogenesis inhibitor for the treatment of solid malignancies. Clinical Therapeutic, 28(11), pp. 1779-
1802.
Sonpavde, G, and Hutson, T.E., (2007) Pazopanib: A novel multitargeted tyrosine kinase inhibitor [Online]: Evolving Terapies 9, pp. 115-119, 23-25,
Available from: http://www.sciencedirect.com/ [Accessed: 20/10/2012].
Tufail , A., Patel , P. & Egan, C., 2010. Bevacizumab for neovascular age related macular degeneration (ABC Trial): multicentre randomised double
masked study.. BMJ.
Wu, H.-C., Huang, C.-T. & Chang, D.-K., 2008. Anti-angiogenic therapeutic drugs for treatment of human cancer. Cancer Molecules, 4(2), pp. 37-45.
Yeung, S. et al. (2009). Medical care of cancer patients. USA: BC Decker Inc.](https://image.slidesharecdn.com/biologicalagentsasdrugs-160811163157/85/Biological-agents-as-drugs-40-320.jpg)